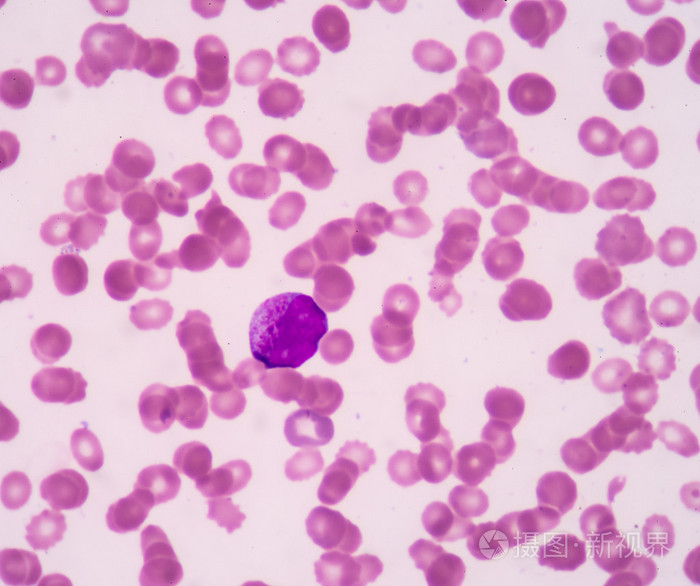
早幼粒细胞.血涂片通常用作随访试验(cb)

复粒细胞图片

▼ 2015503:脂肪颗粒细胞,复粒细胞▼ 2013512:脂肪颗粒细胞,复粒细胞
图片尺寸660x496
其它 2018年细胞形态学培训考试 a:白细胞 b: 复粒细胞 c:肾小管上皮
图片尺寸2558x1761
张时民日常检验工作经验谈如何识别复粒细胞
图片尺寸902x623
复粒细胞.jpg
图片尺寸400x300
如果吞的是脂肪滴的话就是复粒细胞嘛?
图片尺寸500x666
草酸钙针晶束:存在于椭圆形黏液细胞中或随处散在.2.
图片尺寸1080x810
看图识细胞第32期2018年第2次浙江省体液形态学室间质评
图片尺寸402x299
【形态学学习】第一期 粒系_粒细胞
图片尺寸960x729
散点图异常,临检室的老师在进行血常规复片时也发现了幼稚细胞并建议
图片尺寸1000x750
▼ 2012508:肾小管上皮细胞
图片尺寸650x488
细胞形态图谱ppt
图片尺寸1080x810
最通俗的免疫细胞科普!
图片尺寸600x320
临床基本功│粒细胞正常与异常形态
图片尺寸445x314
细胞形态图谱ppt
图片尺寸1080x810
细胞形态图谱ppt
图片尺寸1080x810
箭头所指 "物"名称201840202复粒细胞尿沉渣涂片未染色(普通光镜)400
图片尺寸404x276
【形态学学习】第一期 粒系_粒细胞
图片尺寸960x727
粒细胞的粒细胞介绍
图片尺寸450x344
早幼粒细胞.血涂片通常用作随访试验(cb)
图片尺寸700x586
中性粒细胞偏高是什么意思死而后已白细胞中性粒细胞
图片尺寸3024x3024